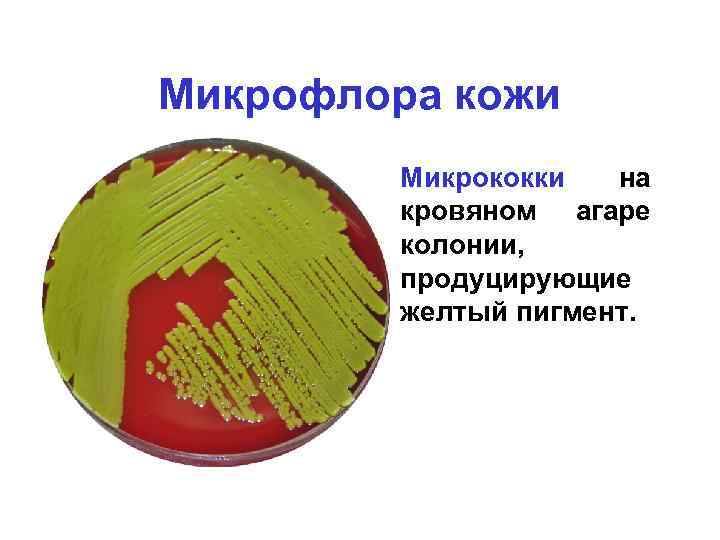
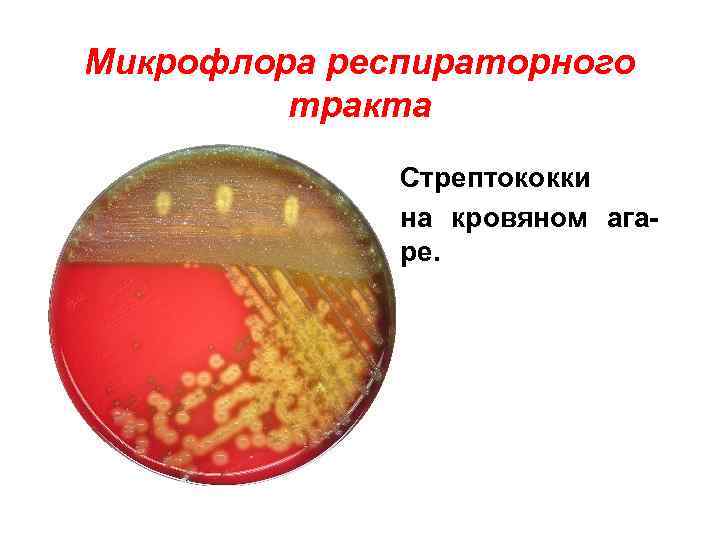
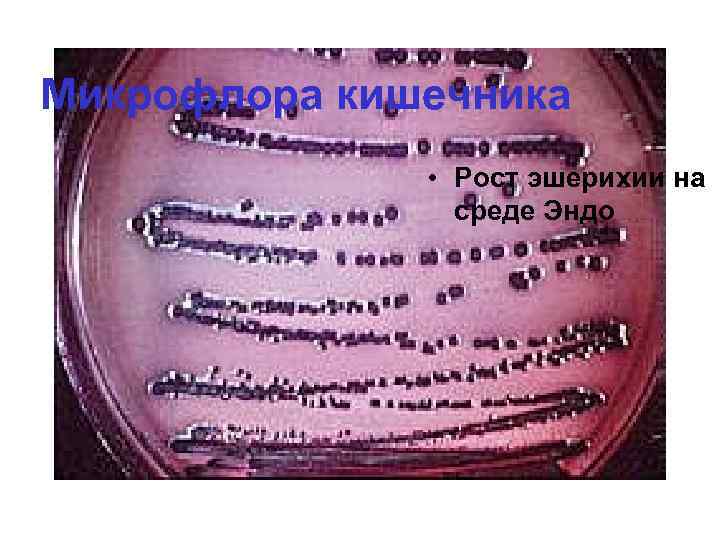

Микрофлора тела человека.ppt
- Количество слайдов: 92
 Микрофлора тела человека Кафарская Л. И.
Микрофлора тела человека Кафарская Л. И.
 Роль нормальной микрофлоры • Микрофлора играет важную роль в поддержании здоровья на оптимальном уровне. • В настоящее время микрофлора рассматривается как метаболически активный орган. • Микрофлора и слизистые находятся в тесном взаимодействии, оказывая взаимное влияние
Роль нормальной микрофлоры • Микрофлора играет важную роль в поддержании здоровья на оптимальном уровне. • В настоящее время микрофлора рассматривается как метаболически активный орган. • Микрофлора и слизистые находятся в тесном взаимодействии, оказывая взаимное влияние
 Микрофлора тела человека • Постоянная часть – облигатная, индигнная, аутохтонная (постоянно входящие в состав нормофлоры и играющие важную роль в метаболизме хозяина). • Факультативная часть –транзиторная (часто встречается у здоровых, состав не постоянный).
Микрофлора тела человека • Постоянная часть – облигатная, индигнная, аутохтонная (постоянно входящие в состав нормофлоры и играющие важную роль в метаболизме хозяина). • Факультативная часть –транзиторная (часто встречается у здоровых, состав не постоянный).
 Функции нормальной микрофлора • Создание колонизационной резистентности (КР), механизма, предотвращающего заселение экзогенными микроорганизмами и их избыточный рост. • Синтез веществ(органические кислоты, перекись), подавляющих рост экзогенных микробов. • Конкуренция за места прикрепления на слизистых и за источники питания. • Стимуляция гуморального и клеточного • Иммунитета, локального иммунитета
Функции нормальной микрофлора • Создание колонизационной резистентности (КР), механизма, предотвращающего заселение экзогенными микроорганизмами и их избыточный рост. • Синтез веществ(органические кислоты, перекись), подавляющих рост экзогенных микробов. • Конкуренция за места прикрепления на слизистых и за источники питания. • Стимуляция гуморального и клеточного • Иммунитета, локального иммунитета
 Функции нормальной микрофлора • Регуляция газового состава кишечника и других полостей организма. • Продукция энзимов, участвующих в • в метаболизме белков, жиров, углеводов. • Детоксикация экзогенных и эндогенных субстратов и метоболитов (естественный биосорбент). • Образование свободных метаболитов • желчи
Функции нормальной микрофлора • Регуляция газового состава кишечника и других полостей организма. • Продукция энзимов, участвующих в • в метаболизме белков, жиров, углеводов. • Детоксикация экзогенных и эндогенных субстратов и метоболитов (естественный биосорбент). • Образование свободных метаболитов • желчи
 Функции нормальной микрофлора • Повышение резистентности эпителиальных клеток к мутагенам (канцерогенам). Морфокинетическая • Антимутагенная • канцеролитическая • Хранилище микробных плазмидных и хромосомных генов • Обеспечение цитопротекции.
Функции нормальной микрофлора • Повышение резистентности эпителиальных клеток к мутагенам (канцерогенам). Морфокинетическая • Антимутагенная • канцеролитическая • Хранилище микробных плазмидных и хромосомных генов • Обеспечение цитопротекции.
 История культурального метода На протяжении многих лет, со времен Пастера и Коха для исследования микрофлоры применяются классические культуральные методы. Получены фундаментальные данные о составе микрофлоры тела человека Выделеныи идентифицированы более 500 видов микроорганизмов В последние годы, проведен мониторинг качественного и количественного изменения по возрастам.
История культурального метода На протяжении многих лет, со времен Пастера и Коха для исследования микрофлоры применяются классические культуральные методы. Получены фундаментальные данные о составе микрофлоры тела человека Выделеныи идентифицированы более 500 видов микроорганизмов В последние годы, проведен мониторинг качественного и количественного изменения по возрастам.
 чувствительность, высокая скорость, прямое определение возбудителя Проводится в несколько этапов. Необходимость стадии электрофореза ПЦР конвенциональная – качественный метод
чувствительность, высокая скорость, прямое определение возбудителя Проводится в несколько этапов. Необходимость стадии электрофореза ПЦР конвенциональная – качественный метод
 • ПЦР в реальном времени
• ПЦР в реальном времени
 ПЦР в реальном времени
ПЦР в реальном времени
 Молекулярно-генетические методы исследования микрофлоры • Для детекции и количественного определения большого количества родов и групп микроорганизмов. • используются группоспецифические, подгруппоспецифические праймеры • Группа C. leptum • 5’ GCACAAGCAGTGGAGT 3’ • Видоспецифические праймеры – детекция определенных видов микроорганизмов.
Молекулярно-генетические методы исследования микрофлоры • Для детекции и количественного определения большого количества родов и групп микроорганизмов. • используются группоспецифические, подгруппоспецифические праймеры • Группа C. leptum • 5’ GCACAAGCAGTGGAGT 3’ • Видоспецифические праймеры – детекция определенных видов микроорганизмов.
 Молекулярно-генетические методы исследования микрофлоры • Создание праймера 2 -х этапный процесс – «записать» нуклеотидную последовательность и синтез праймера. • Определение нуклеотидной последовательности Секвенирование.
Молекулярно-генетические методы исследования микрофлоры • Создание праймера 2 -х этапный процесс – «записать» нуклеотидную последовательность и синтез праймера. • Определение нуклеотидной последовательности Секвенирование.
 Новые методы изучения микрофлоры • В 1999 году группа ученых из (Франция) и Университета Ридинга (Великобритания) применили для исследования микробной популяции кишечника метод секвенирования генов 16 S РНК • Идеальный маркер для идентификации микроорганизмов ген, кодирующий 16 S рибосомальную РНК. • Этот ген есть в геноме всех бактерий и архей, но отсутствует у эукариот и вирусов, имеет как консервативные участки, одинаковые у всех прокариот, так и видоспецифичные. • Нуклеотидные последовательности 16 S РНК всех известных бактерий общедоступны (ген банк).
Новые методы изучения микрофлоры • В 1999 году группа ученых из (Франция) и Университета Ридинга (Великобритания) применили для исследования микробной популяции кишечника метод секвенирования генов 16 S РНК • Идеальный маркер для идентификации микроорганизмов ген, кодирующий 16 S рибосомальную РНК. • Этот ген есть в геноме всех бактерий и архей, но отсутствует у эукариот и вирусов, имеет как консервативные участки, одинаковые у всех прокариот, так и видоспецифичные. • Нуклеотидные последовательности 16 S РНК всех известных бактерий общедоступны (ген банк).
 Новые методы изучения микрофлоры • Только 24% полученных последовательностей 16 S РНК принадлежали известным ранее микроорганизмам. Три четверти представителей микрофлоры не культивируются.
Новые методы изучения микрофлоры • Только 24% полученных последовательностей 16 S РНК принадлежали известным ранее микроорганизмам. Три четверти представителей микрофлоры не культивируются.
 Микрофлора кожи • Аэробные коринеформные бактерии • Corynebacterium – подмышечные впадины, грудная клетка, промежность, кожа носа. • Brevibacterium – на руках, стопах ног. • Анаэробные коринеформные. • Propionibacterium acnes – на крыльях носа, головы спины(сальные железы). • На фоне гормональной перестройки играют значительную роль в возникновении юношеских acne vulgaris
Микрофлора кожи • Аэробные коринеформные бактерии • Corynebacterium – подмышечные впадины, грудная клетка, промежность, кожа носа. • Brevibacterium – на руках, стопах ног. • Анаэробные коринеформные. • Propionibacterium acnes – на крыльях носа, головы спины(сальные железы). • На фоне гормональной перестройки играют значительную роль в возникновении юношеских acne vulgaris
 Микрофлора кожи • Коринеформные обнаруживают чаще кожных складках. – в
Микрофлора кожи • Коринеформные обнаруживают чаще кожных складках. – в
 Микрофлора кожи • Propionibacterium. Облигатно анаэробные грамположительные неспоробразующие. • Обнаруживаются в глубоких слоях кожи.
Микрофлора кожи • Propionibacterium. Облигатно анаэробные грамположительные неспоробразующие. • Обнаруживаются в глубоких слоях кожи.
 Микрофлора кожи • Микрококки • Staphylococcus aureus – нос, промежность, подмышечные области. • Staphylococcus epidermidis – кожа рук, • ног, лба. • Micrococcus luteus – в кожных складках, бедрах, чаще в пубертатный период. • Анаэробны кокки –Peptosreptococcus – • кожа лба.
Микрофлора кожи • Микрококки • Staphylococcus aureus – нос, промежность, подмышечные области. • Staphylococcus epidermidis – кожа рук, • ног, лба. • Micrococcus luteus – в кожных складках, бедрах, чаще в пубертатный период. • Анаэробны кокки –Peptosreptococcus – • кожа лба.
 Микрофлора кожи • Стафилококки
Микрофлора кожи • Стафилококки
 Микрофлора кожи • Стафилококки – электронная микроскопия
Микрофлора кожи • Стафилококки – электронная микроскопия
 Микрофлора кожи • Эпидермальный стафилококк – рост на кровяном агаре без гемолиза.
Микрофлора кожи • Эпидермальный стафилококк – рост на кровяном агаре без гемолиза.
Микрофлора кожи • Микрококки на кровяном агаре колонии, продуцирующие желтый пигмент.
Микрофлора кожи • Микрококки на кровяном агаре колонии, продуцирующие желтый пигмент.
 Микрофлора кожи • Бациллытранзиторно
Микрофлора кожи • Бациллытранзиторно
 Микрофлора кожи • Бациллы гемолиз • на кровяном агаре.
Микрофлора кожи • Бациллы гемолиз • на кровяном агаре.
 Микрофлора кожи • Микрофлора наружных слуховых проходов. • • Коагулозонегативные стафилококки, Коринебактерии. При патологических процессах – Псевдомонады, протеи, эшерихии.
Микрофлора кожи • Микрофлора наружных слуховых проходов. • • Коагулозонегативные стафилококки, Коринебактерии. При патологических процессах – Псевдомонады, протеи, эшерихии.
 Микрофлора респираторного тракта • Ротовая полость • Стрептококки – Streptococcus salivarius. • Стафилококки – S. aureus, S. epidermidis, анаэробные кокки в слюне. • Haemophilus inffluenzae – часто у здоровых. • Облигатноанаэробные неспорообразующие анаэробы(превотеллы, порфиромонасы) • Лактобактерии, лептотрихии. • Грибы рода Candida
Микрофлора респираторного тракта • Ротовая полость • Стрептококки – Streptococcus salivarius. • Стафилококки – S. aureus, S. epidermidis, анаэробные кокки в слюне. • Haemophilus inffluenzae – часто у здоровых. • Облигатноанаэробные неспорообразующие анаэробы(превотеллы, порфиромонасы) • Лактобактерии, лептотрихии. • Грибы рода Candida
Микрофлора респираторного тракта • Стрептококки • на кровяном агаре.
Микрофлора респираторного тракта • Стрептококки • на кровяном агаре.
 Микрофлора респираторного тракта • Стрептококки • ( Streptococcus • mutans)
Микрофлора респираторного тракта • Стрептококки • ( Streptococcus • mutans)
 Микрофлора респираторного тракта • Стрептококки – • электронная микроскопия.
Микрофлора респираторного тракта • Стрептококки – • электронная микроскопия.
 • Гемофильные палочки
• Гемофильные палочки
 Микрофлора носоглотки • Небные миндалины- гемолитические стрептококки(S. pyogenes), S. pneumoniae, анаэробные кокки, H. influenza, неспорообразующие анаэробы. • Нос - S. aureus, S. epidermidis, непатогенные нейссерии, иногда коринебактерии. • Трахея, бронхиолы, альвеолыстерильны.
Микрофлора носоглотки • Небные миндалины- гемолитические стрептококки(S. pyogenes), S. pneumoniae, анаэробные кокки, H. influenza, неспорообразующие анаэробы. • Нос - S. aureus, S. epidermidis, непатогенные нейссерии, иногда коринебактерии. • Трахея, бронхиолы, альвеолыстерильны.
 Наличие внешних источников здорового бактериального представительства (мать и родственники, близко контактирующие с ребенком Грудное вскармливание (противомикробные компоненты грудного молока) Селективное заселение представителей нормальной микрофлоры из множества микроорганизмов окружающей среды. Необходимые условия формирования нормальной микрофлоры
Наличие внешних источников здорового бактериального представительства (мать и родственники, близко контактирующие с ребенком Грудное вскармливание (противомикробные компоненты грудного молока) Селективное заселение представителей нормальной микрофлоры из множества микроорганизмов окружающей среды. Необходимые условия формирования нормальной микрофлоры
 Соединения с иммунологическими свойствами в грудном молоке Противомикробные соединения Иммуноглобины: slg. A, Slg. G, Slg. M Лактоферрин, лактоферрин В и Н Лизоцим Лактопероксидаза Антитела к-казеин и α-лактальбумин Хаптокоррин (Haptocorrin) Муцины Лактадхерин (Lactadherin) Свободный секреторный компонент Олигосахариды и пребиотики Жирные кислоты Материнские лейкоциты и цитокины s. CD 14 Комплемент и дополнительные рецепторы β- дефензин-1 Бифидофактор Устойчивые/стимулирующие соединения Цитокины II-10 и TGFβ Антиидиотипические антитела Соединения развития иммунитета Макрофаги Нейтрофилы Лимфоциты Цитокины Факторы роста Гормоны Молочные пептиды Полиненасыщенные жирные кислоты с длинной цепью Нуклеотиды Молекулы адгезии Противовоспалительные соединения Цитокины: II-10 и TGFβ Антагонист рецептора II-1 TNFα и рецепторы II-6 s. CD 14 Молекулы адгезии Полиненасыщенные жирные кислоты с длинной цепью Гормоны и факторы роста Остеопротегерин Полиненасыщенные жирные кислоты с длинной цепью Гормоны и факторы роста
Соединения с иммунологическими свойствами в грудном молоке Противомикробные соединения Иммуноглобины: slg. A, Slg. G, Slg. M Лактоферрин, лактоферрин В и Н Лизоцим Лактопероксидаза Антитела к-казеин и α-лактальбумин Хаптокоррин (Haptocorrin) Муцины Лактадхерин (Lactadherin) Свободный секреторный компонент Олигосахариды и пребиотики Жирные кислоты Материнские лейкоциты и цитокины s. CD 14 Комплемент и дополнительные рецепторы β- дефензин-1 Бифидофактор Устойчивые/стимулирующие соединения Цитокины II-10 и TGFβ Антиидиотипические антитела Соединения развития иммунитета Макрофаги Нейтрофилы Лимфоциты Цитокины Факторы роста Гормоны Молочные пептиды Полиненасыщенные жирные кислоты с длинной цепью Нуклеотиды Молекулы адгезии Противовоспалительные соединения Цитокины: II-10 и TGFβ Антагонист рецептора II-1 TNFα и рецепторы II-6 s. CD 14 Молекулы адгезии Полиненасыщенные жирные кислоты с длинной цепью Гормоны и факторы роста Остеопротегерин Полиненасыщенные жирные кислоты с длинной цепью Гормоны и факторы роста
 Кишечник-часть иммунной системы. В реализации иммунных механизмов на уровне интестинального тракта принимают участие три ключевых и одновременно взаимосвязанных компонента: - Нормальная микрофлора. - Лимфоидная ткань, ассоциированная со слизистой оболочкой кишечника - Цитокины, как фактор межклеточного взаимодействия.
Кишечник-часть иммунной системы. В реализации иммунных механизмов на уровне интестинального тракта принимают участие три ключевых и одновременно взаимосвязанных компонента: - Нормальная микрофлора. - Лимфоидная ткань, ассоциированная со слизистой оболочкой кишечника - Цитокины, как фактор межклеточного взаимодействия.

 Молекулярно-генетические методы в изучении микрофлоры Использование молекулярно-генетических методов коренным образом изменило наши представления о составе микрофлоры Интестинальная микрофлора представлена преимущественно облигатно анаэробными группами микроорганизмов Большинство видов микроорганизмов относится к некультивируемым микроорганизмам
Молекулярно-генетические методы в изучении микрофлоры Использование молекулярно-генетических методов коренным образом изменило наши представления о составе микрофлоры Интестинальная микрофлора представлена преимущественно облигатно анаэробными группами микроорганизмов Большинство видов микроорганизмов относится к некультивируемым микроорганизмам
 Преобладающие группы бактерий 1 доминирующая группа до 43% Clostridium coccoides group Clostridium, Eubacterium, Ruminococcus, Coprococcus, Dorea, Lachnospira, Roseburia and Butyrivibrio 2 - доминирующая Clostridium leptum группа 19 -25% Anaerqfilum Clostridium, Eubacterium, Ruminococcus 3 - группа Cytophaga-Flavobacter-Bacteroides 1 - минорная группа Bifidobacterium около 5 -10% 2 – минорная группа Lactobadllus, Lactococcus, Enterococcus, Streptococcus Leuconostoc
Преобладающие группы бактерий 1 доминирующая группа до 43% Clostridium coccoides group Clostridium, Eubacterium, Ruminococcus, Coprococcus, Dorea, Lachnospira, Roseburia and Butyrivibrio 2 - доминирующая Clostridium leptum группа 19 -25% Anaerqfilum Clostridium, Eubacterium, Ruminococcus 3 - группа Cytophaga-Flavobacter-Bacteroides 1 - минорная группа Bifidobacterium около 5 -10% 2 – минорная группа Lactobadllus, Lactococcus, Enterococcus, Streptococcus Leuconostoc
 Особенности микрофлоры у здоровых детей раннего возраста. n n n n n Бифидобактерии облигатная флора детей раннего возраста. К концу 2 недели жизни обнаружены у 40 -60% новорожденных. Доминируют у 96%-100% клинически здоровых детей, на грудном вскармливании, у 75% на искусственном. У взрослых бифидобактерии составляют менее 10% микробиоты. Их присутствие жизненно важно. Важнейшая функция создание КР, препятствуют транслокации условнопатогенных из кишечника. Концентрация 109 -1010 мт От 1 до 4 видов бифидобактерий B. longum, B. adolescentis, B. breve, B. pseudocatenulatum
Особенности микрофлоры у здоровых детей раннего возраста. n n n n n Бифидобактерии облигатная флора детей раннего возраста. К концу 2 недели жизни обнаружены у 40 -60% новорожденных. Доминируют у 96%-100% клинически здоровых детей, на грудном вскармливании, у 75% на искусственном. У взрослых бифидобактерии составляют менее 10% микробиоты. Их присутствие жизненно важно. Важнейшая функция создание КР, препятствуют транслокации условнопатогенных из кишечника. Концентрация 109 -1010 мт От 1 до 4 видов бифидобактерий B. longum, B. adolescentis, B. breve, B. pseudocatenulatum
 Микрофлора кишечника • Лактобактерии. . Облигатная флора. К концу 1 -го месяца жизни обнаружены у 57%детей, находящихся на грудном вскармливании • В мере взросления их количество увеличивалось. • Содержание в большей степени зависит от вводимых кисломолочных продуктов. • Количество 106 – 108 в 1 г.
Микрофлора кишечника • Лактобактерии. . Облигатная флора. К концу 1 -го месяца жизни обнаружены у 57%детей, находящихся на грудном вскармливании • В мере взросления их количество увеличивалось. • Содержание в большей степени зависит от вводимых кисломолочных продуктов. • Количество 106 – 108 в 1 г.
 Микрофлора кишечника • Бактероиды. Неспоробразующие грамотрицательные анаэробы. • Способны отщеплять остатки фукозы от поверхности клеток хозяина используя в качестве источника энергии или как строительный материал для синтеза различных молекул, включая богатые фукозой капсулы • В 8 месяцев – 80% • В 10 месяцев у 100%. • Высокочувствительны к действию кислорода, необходимо снижение О-В в кишечнике. Концентрация 1091010 в 1 г.
Микрофлора кишечника • Бактероиды. Неспоробразующие грамотрицательные анаэробы. • Способны отщеплять остатки фукозы от поверхности клеток хозяина используя в качестве источника энергии или как строительный материал для синтеза различных молекул, включая богатые фукозой капсулы • В 8 месяцев – 80% • В 10 месяцев у 100%. • Высокочувствительны к действию кислорода, необходимо снижение О-В в кишечнике. Концентрация 1091010 в 1 г.
 Особенности микрофлоры у здоровых детей раннего возраста. «Условно бактероиды» - многочисленная группа грамотрицательных, палочковидных анаэробных бактерий. Роды: Bacteroides, Alistipes, Porphiromonas, Prevotella Содержание резко повышается и достигает концентрации взрослых 109 -10 КОЕ/г. к 6 -7 месяцам. Данные микроорганизмы стимулируют формирование иммунной системы ребенка, ускоряя созревание Ig. A- и Ig. G-секретирующих клеток «Биологический реактор» производство энергии
Особенности микрофлоры у здоровых детей раннего возраста. «Условно бактероиды» - многочисленная группа грамотрицательных, палочковидных анаэробных бактерий. Роды: Bacteroides, Alistipes, Porphiromonas, Prevotella Содержание резко повышается и достигает концентрации взрослых 109 -10 КОЕ/г. к 6 -7 месяцам. Данные микроорганизмы стимулируют формирование иммунной системы ребенка, ускоряя созревание Ig. A- и Ig. G-секретирующих клеток «Биологический реактор» производство энергии
 Особенности микрофлоры толстого кишечника у клинически здоровых детей раннего возраста. n Лецитиназонегативные n n n клостридии у 45, 7% в конце 1 -го месяца жизни, у 80 -100% к концу 1 года. Лецитиназопозитивные у 3040%. Производят бутират нутритивный фактор для колоноцитов. Стимулируют пролиферацию кишечного эпителия. К клостридиям пока отнесены Сегментированные фрагментарные филаментозные бактерии, не культивируются
Особенности микрофлоры толстого кишечника у клинически здоровых детей раннего возраста. n Лецитиназонегативные n n n клостридии у 45, 7% в конце 1 -го месяца жизни, у 80 -100% к концу 1 года. Лецитиназопозитивные у 3040%. Производят бутират нутритивный фактор для колоноцитов. Стимулируют пролиферацию кишечного эпителия. К клостридиям пока отнесены Сегментированные фрагментарные филаментозные бактерии, не культивируются
 Особенности микрофлоры толстого кишечника у клинически здоровых детей раннего возраста. К клостридиям отнесены n n n n Эубактерии –грамположительные, неспорообразующие палочковидные, анаэробы. В 10 месяцев у 33, 3%, в 1 год 46, 5% в количестве Lg 10, 0+0, 4. Пептострептококки облигатно анаэрбные, кокки. Встречаются у 33% -53, 9% до 1 года. Концентрация Lg 9, 9+0, 5. Руминококки Сегментированные филаментозные бактерии, некультивируются
Особенности микрофлоры толстого кишечника у клинически здоровых детей раннего возраста. К клостридиям отнесены n n n n Эубактерии –грамположительные, неспорообразующие палочковидные, анаэробы. В 10 месяцев у 33, 3%, в 1 год 46, 5% в количестве Lg 10, 0+0, 4. Пептострептококки облигатно анаэрбные, кокки. Встречаются у 33% -53, 9% до 1 года. Концентрация Lg 9, 9+0, 5. Руминококки Сегментированные филаментозные бактерии, некультивируются
 Segmented filamentous bacteria (SFB) – некультивируемая группа микроорганизмов, грамположительные, пока отнесены к клостридиям Находятся в тесном контакте с эпителицитами тонкого кишечника (в инвагинациях мембраны) Просеквенированы геномы нескольких изолятов • Играют ключевую роль в постнатальном созревании иммунной функции толстой кишки • Стимулируют Тн 17 лимфоциты.
Segmented filamentous bacteria (SFB) – некультивируемая группа микроорганизмов, грамположительные, пока отнесены к клостридиям Находятся в тесном контакте с эпителицитами тонкого кишечника (в инвагинациях мембраны) Просеквенированы геномы нескольких изолятов • Играют ключевую роль в постнатальном созревании иммунной функции толстой кишки • Стимулируют Тн 17 лимфоциты.
 Микрофлора кишечника • Клостридии. • Clostridium difficile. • Присутствуют в небольшом количестве. Их популяция • Резко возрастает при использовании некоторых антибиотиковклиндамицин. Вызывают псевдомембранозный колит
Микрофлора кишечника • Клостридии. • Clostridium difficile. • Присутствуют в небольшом количестве. Их популяция • Резко возрастает при использовании некоторых антибиотиковклиндамицин. Вызывают псевдомембранозный колит
 Микрофлора кишечника • Эшерихии. • Количество 106 -108 в 1 г. • Синтезируют 9 витаминов.
Микрофлора кишечника • Эшерихии. • Количество 106 -108 в 1 г. • Синтезируют 9 витаминов.
 Микрофлора кишечника • Эшерихии электронная микроскопия
Микрофлора кишечника • Эшерихии электронная микроскопия
Микрофлора кишечника • Рост эшерихии на среде Эндо
Микрофлора кишечника • Рост эшерихии на среде Эндо
 Микрофлора кишечника • Клебсиеллы. • В высокой концентрации у детей • 80 -100% детей в возрасте 7 -12 месяцев. • После 1, 5 лет элиминируются. • Транзиторная микрофлора
Микрофлора кишечника • Клебсиеллы. • В высокой концентрации у детей • 80 -100% детей в возрасте 7 -12 месяцев. • После 1, 5 лет элиминируются. • Транзиторная микрофлора
 Микрофлора кишечника • Рост клебсиелл на агаре эндо.
Микрофлора кишечника • Рост клебсиелл на агаре эндо.
 Микрофлора кишечника Псевдомонады –окраска по Граму. • Псевдомонады встречаются редко 3 -5%
Микрофлора кишечника Псевдомонады –окраска по Граму. • Псевдомонады встречаются редко 3 -5%
 Микрофлора кишечника • Кандида
Микрофлора кишечника • Кандида
 Микрофлора кишечника • Стафилококки. • Коагулазонегативные стафилококки у 80 -100%, коагулазопозитивные у 60% детей раннего возраста.
Микрофлора кишечника • Стафилококки. • Коагулазонегативные стафилококки у 80 -100%, коагулазопозитивные у 60% детей раннего возраста.
 Микрофлора кишечника • Стрептококки
Микрофлора кишечника • Стрептококки
 Микрофлора кишечника • Стрептококки электронная микроскопия
Микрофлора кишечника • Стрептококки электронная микроскопия
 Микрофлора кишечника • Энтерококк
Микрофлора кишечника • Энтерококк
 Микрофлора кишечника • Энтерококк электронная микроскопия. • Нормальный представитель микрофлоры. • Концентрация 108 106 -
Микрофлора кишечника • Энтерококк электронная микроскопия. • Нормальный представитель микрофлоры. • Концентрация 108 106 -
 Микрофлора кишечника • Бациллы. • Транзиторная микрофлора. • У здоровых детей –редко.
Микрофлора кишечника • Бациллы. • Транзиторная микрофлора. • У здоровых детей –редко.
 Особенности микрофлоры у клинически здоровых детей раннего возраста. • Высокие популяционные уровни бифидобактерий и бактероидов у 100% детей. • Лактобактерии не у всех. • Высокая частота выделения и концентрация аллохтонных микроорганизмов: • Коагулазопозитивные стафилококки • Цитратассимилирующие энтеробактерии • Эшерихии с низкой биохимической активностью и продуцирующие гемолизины. • Лецитиназопозитивные клостридии. • К концу первого года жизни происходит полная или частичная элиминация условнопатогенных бактерий
Особенности микрофлоры у клинически здоровых детей раннего возраста. • Высокие популяционные уровни бифидобактерий и бактероидов у 100% детей. • Лактобактерии не у всех. • Высокая частота выделения и концентрация аллохтонных микроорганизмов: • Коагулазопозитивные стафилококки • Цитратассимилирующие энтеробактерии • Эшерихии с низкой биохимической активностью и продуцирующие гемолизины. • Лецитиназопозитивные клостридии. • К концу первого года жизни происходит полная или частичная элиминация условнопатогенных бактерий
 Микрофлора и иммунная система кишечника
Микрофлора и иммунная система кишечника
 Нарушение качественного и количественного состава микрофлоры – опасно для здоровья. Основными механизмами, участвующими в контроле качественного и количественного состава микроорганизмов, являются факторы естественной резистентности и иммунологической защиты, созревание которых происходит по мере взросления ребенка. Контакты с бактериальными антигенами определяют созревание иммунной системы. Состав микрофлоры кишечника должен косвенно отражать особенности физиологического состояния как защитных, так и других систем организма в различные периоды жизни
Нарушение качественного и количественного состава микрофлоры – опасно для здоровья. Основными механизмами, участвующими в контроле качественного и количественного состава микроорганизмов, являются факторы естественной резистентности и иммунологической защиты, созревание которых происходит по мере взросления ребенка. Контакты с бактериальными антигенами определяют созревание иммунной системы. Состав микрофлоры кишечника должен косвенно отражать особенности физиологического состояния как защитных, так и других систем организма в различные периоды жизни
 Заключение • Микрофлора кишечника рассматривается как метаболически активный орган • Преобладающими группами микроорганизмов у людей более старшего возраста являются группы клостридий • Бифидобактерии важнейшая и доминирующая группа микроорганизмов у грудных младенцев
Заключение • Микрофлора кишечника рассматривается как метаболически активный орган • Преобладающими группами микроорганизмов у людей более старшего возраста являются группы клостридий • Бифидобактерии важнейшая и доминирующая группа микроорганизмов у грудных младенцев
 Микрофлора мочеполового тракта • Наружные половые органы • Стафилококки, зеленящие стрептококки, • Энтерококки, пептострептококки, коринебактерии, энтеробактерии, неспорообразующие анаэробы, дрожжи.
Микрофлора мочеполового тракта • Наружные половые органы • Стафилококки, зеленящие стрептококки, • Энтерококки, пептострептококки, коринебактерии, энтеробактерии, неспорообразующие анаэробы, дрожжи.
 Микроэкология влагалища • Половые пути женщины: • Плоский эпителий влагалища • Цилиндрический эпителий шейки матки • Вагинальный секрет
Микроэкология влагалища • Половые пути женщины: • Плоский эпителий влагалища • Цилиндрический эпителий шейки матки • Вагинальный секрет
 Микроэкология влагалища • Вагинальный эпителий –сквамозный многослойный эпителий, созревание эпителиоцитов находится под контролем гормонов яичников(индуцируют накопление гликогена в вагинальном эпителии). • Гликоген расщепляется лактобакте • риями с продукцией молочной кислоты. • Низкие значения р. Н
Микроэкология влагалища • Вагинальный эпителий –сквамозный многослойный эпителий, созревание эпителиоцитов находится под контролем гормонов яичников(индуцируют накопление гликогена в вагинальном эпителии). • Гликоген расщепляется лактобакте • риями с продукцией молочной кислоты. • Низкие значения р. Н
 Вагинальная микрофлора • Вагинальный эпителиоцит. • К нему адгезированы • лактобактерии(па лочки Додерлайна). • Поддерживают КР • Влагалища, продуцируют молочную кислоту, перекись • водорода.
Вагинальная микрофлора • Вагинальный эпителиоцит. • К нему адгезированы • лактобактерии(па лочки Додерлайна). • Поддерживают КР • Влагалища, продуцируют молочную кислоту, перекись • водорода.
 Вагинальная микрофлора • Вагинальные лактобактерии. • Количество их у женщин репродуктивного возраста 107 -108 Типичные представители: L. acidophilus L. fermentum L. plantarum L. casei
Вагинальная микрофлора • Вагинальные лактобактерии. • Количество их у женщин репродуктивного возраста 107 -108 Типичные представители: L. acidophilus L. fermentum L. plantarum L. casei
 Лактобактерии препятствуют контаминации вагинального тракта экзогенными микроорганизмами и таким образом обеспечивают колонизационную резистентность. Антибактериальная активность прежде всего связана с выработкой в процессе брожения молочной и других органических кислот, что обеспечивает низкое содержание р. Н, а также – способность наза продуцировать перекись водорода д
Лактобактерии препятствуют контаминации вагинального тракта экзогенными микроорганизмами и таким образом обеспечивают колонизационную резистентность. Антибактериальная активность прежде всего связана с выработкой в процессе брожения молочной и других органических кислот, что обеспечивает низкое содержание р. Н, а также – способность наза продуцировать перекись водорода д
 Вагинальная микрофлора Выявляются у 7 -12% здоровых женщин (во время беременности – выше 20%) и концентрациях варьируют от 103 до 107 КОЕ/мл. Выделяют большое количество кислых продуктов, тем способствуя поддержанию во влагалище кислой среды (низкой р. Н)
Вагинальная микрофлора Выявляются у 7 -12% здоровых женщин (во время беременности – выше 20%) и концентрациях варьируют от 103 до 107 КОЕ/мл. Выделяют большое количество кислых продуктов, тем способствуя поддержанию во влагалище кислой среды (низкой р. Н)
 Пептосрептококки Относятся к представителям нормальной флоры генитального тракта. Частота их выделения в норме варьирует от 40 до 90 % случаев, а количество анаэробных кокков в вагинальном отделяемом составляет от 103 до 104 КОЕ/мл .
Пептосрептококки Относятся к представителям нормальной флоры генитального тракта. Частота их выделения в норме варьирует от 40 до 90 % случаев, а количество анаэробных кокков в вагинальном отделяемом составляет от 103 до 104 КОЕ/мл .
 Пропионобактерии . Типичный представитель – P. аcnes, которые могут быть выделены с частотой до 25% в количестве 104 КОЕ/мл (в норме) наза д
Пропионобактерии . Типичный представитель – P. аcnes, которые могут быть выделены с частотой до 25% в количестве 104 КОЕ/мл (в норме) наза д
 Превотеллы Неспоорбразующие, грамотрицательные анвэробные палочки. Основной вид – P. bivia и P. disiens. В норме частота встречаемости может достигать 60%, количественный уровень не превышает в норме 104 КОЕ/мл
Превотеллы Неспоорбразующие, грамотрицательные анвэробные палочки. Основной вид – P. bivia и P. disiens. В норме частота встречаемости может достигать 60%, количественный уровень не превышает в норме 104 КОЕ/мл
 Mobiluncus Выделяются только у 5% здоровых женщин. Основное значение приобретают у женщин с бектериальным вагинозом. Отмечается значительное увеличение концентрации этих бактерий на фоне снижения уровня вагинальных лактобактерий, при этом частота контаминации достигает от 30% до 50% случаев. Обладают способностью прикрепляться к эпителиоцитам влагалища. Кроме того, у них обнаружены муколитические ферменты: муциназа, нейраминидаза
Mobiluncus Выделяются только у 5% здоровых женщин. Основное значение приобретают у женщин с бектериальным вагинозом. Отмечается значительное увеличение концентрации этих бактерий на фоне снижения уровня вагинальных лактобактерий, при этом частота контаминации достигает от 30% до 50% случаев. Обладают способностью прикрепляться к эпителиоцитам влагалища. Кроме того, у них обнаружены муколитические ферменты: муциназа, нейраминидаза
 Вагинальная микрофлора • Вейлонелла облигатно анаэробные грамотрицательные кокки.
Вагинальная микрофлора • Вейлонелла облигатно анаэробные грамотрицательные кокки.
 • «Ключевые клетки»
• «Ключевые клетки»
 • «Ключевые клетки» • Мобилюнкусы
• «Ключевые клетки» • Мобилюнкусы

 Причины дисбактериоза • Химиотерапевтический – назаначение • антибиотиков (ампициллин, клиндамицин. • Постлучевой – воздействие ионизирующей радиации(аплазия костного мозга, гибель микрофлоры и эпителиоцитов кишечника). • Постинфекционный – после перенесенных инфекций. • Воздействие стрессовых факторов.
Причины дисбактериоза • Химиотерапевтический – назаначение • антибиотиков (ампициллин, клиндамицин. • Постлучевой – воздействие ионизирующей радиации(аплазия костного мозга, гибель микрофлоры и эпителиоцитов кишечника). • Постинфекционный – после перенесенных инфекций. • Воздействие стрессовых факторов.
 Коррекция микрофлоры кишечника • Биологически активные вещества: • Диетические добавки-естественые питательные вещества(витамины, минералы, протеины, ферменты)+ микроорганизмы(пробиотики), используют как • дополнение к основной пище. • Функциональное питание – готовые для продажи пищевые продукты, в которые добавляют биопрепараты. Это модифицированные продукты, которые улучшают состояние здоровья более оптимально, чем исходный продукт (бифидокефир).
Коррекция микрофлоры кишечника • Биологически активные вещества: • Диетические добавки-естественые питательные вещества(витамины, минералы, протеины, ферменты)+ микроорганизмы(пробиотики), используют как • дополнение к основной пище. • Функциональное питание – готовые для продажи пищевые продукты, в которые добавляют биопрепараты. Это модифицированные продукты, которые улучшают состояние здоровья более оптимально, чем исходный продукт (бифидокефир).
 Функциональное питание
Функциональное питание
 Коррекция микрофлоры кишечника • Пробиотики-живые микроорганизмы(бифидобак терии, лактобактерии), нормофлора кишечника здорового человека. Могут включаться в питание, как биодобавки.
Коррекция микрофлоры кишечника • Пробиотики-живые микроорганизмы(бифидобак терии, лактобактерии), нормофлора кишечника здорового человека. Могут включаться в питание, как биодобавки.
 Критерии отбора перспективных штаммовпробиотиков. • Происхождение штамма- типичный для данной экологической ниши. • Жизнеспособность – выживаемость в ЖКТ. • Способность к адгезии. • Высокая антагонистическая активность. • Иммуномодулирующие свойства • Модуляция метаболической активности индигенной флоры • Безопасность • Производственные характеристики
Критерии отбора перспективных штаммовпробиотиков. • Происхождение штамма- типичный для данной экологической ниши. • Жизнеспособность – выживаемость в ЖКТ. • Способность к адгезии. • Высокая антагонистическая активность. • Иммуномодулирующие свойства • Модуляция метаболической активности индигенной флоры • Безопасность • Производственные характеристики
 Влияние пробиотических препаратов на состав микрофлоры кишечника у детей раннего возраста v. Пробиотик – эффективно восстанавливает молочнокислую флору. v. Не приводит к элиминации условнопатогенных бактерий. v. Постоянная контаминация микроорганизмами окружающей среды v. Основными механизмами, участвующими в контроле качественного и количественного состава микроорганизмов, являются факторы естественной резистентности и иммунологической защиты, созревание которых происходит по мере взросления ребенка
Влияние пробиотических препаратов на состав микрофлоры кишечника у детей раннего возраста v. Пробиотик – эффективно восстанавливает молочнокислую флору. v. Не приводит к элиминации условнопатогенных бактерий. v. Постоянная контаминация микроорганизмами окружающей среды v. Основными механизмами, участвующими в контроле качественного и количественного состава микроорганизмов, являются факторы естественной резистентности и иммунологической защиты, созревание которых происходит по мере взросления ребенка
 Бифидосодержащие • Монокомпонентные - бифидумбактерин, • Поликомпонентные -Линекс (B. infantis, L. acidophilus, E. faecium), Примадофилус • Бифиформ (В. longum и E. faecium). • Комбинированные и сорбированные • Бифилиз сухой (B. bifidum и лизоцим). • Пробифор(B. bifidum, адсорбированные на активированном угле
Бифидосодержащие • Монокомпонентные - бифидумбактерин, • Поликомпонентные -Линекс (B. infantis, L. acidophilus, E. faecium), Примадофилус • Бифиформ (В. longum и E. faecium). • Комбинированные и сорбированные • Бифилиз сухой (B. bifidum и лизоцим). • Пробифор(B. bifidum, адсорбированные на активированном угле
 Пробиотические препараты
Пробиотические препараты
 Пребиотические продукты • 1995 год – Неперевариваемые компоненты пищи, способные избирательно стимулировать рост 1 и 2 видов микроорганизмов в толстой кишке. • В настоящее время пребиотик и бифидогенный факторы уравнены. • инулин и олигофруктоза, галактоолигосахариды • Не адсорбируются, не расщепляются в верхних отделах ЖКТ
Пребиотические продукты • 1995 год – Неперевариваемые компоненты пищи, способные избирательно стимулировать рост 1 и 2 видов микроорганизмов в толстой кишке. • В настоящее время пребиотик и бифидогенный факторы уравнены. • инулин и олигофруктоза, галактоолигосахариды • Не адсорбируются, не расщепляются в верхних отделах ЖКТ
 Лактосодержащие • Моносодержащие • Лактобактерин сухой (L. plantarum 8 RA 3) • Поли-компонентные - Ацилакт сухой (L. acidophilus - 3 разных штамма). • Аципол (L. acidophilus и полисахарид кефирных грибков)
Лактосодержащие • Моносодержащие • Лактобактерин сухой (L. plantarum 8 RA 3) • Поли-компонентные - Ацилакт сухой (L. acidophilus - 3 разных штамма). • Аципол (L. acidophilus и полисахарид кефирных грибков)
 Пребиотические продукты • Пребиотики -цепи, состоящие из 3 - 10 мономеров углевода • Низкий гликемичсекий индекс • Низкое содержание калорий • Устойчивы к действию пищеварительных ферментов человека ( связи между фруктозой и глюкозой, с короткоцепочечными жирными кислотами) • Большинство бифидобактерий обладает соответствующим β-fructosidase
Пребиотические продукты • Пребиотики -цепи, состоящие из 3 - 10 мономеров углевода • Низкий гликемичсекий индекс • Низкое содержание калорий • Устойчивы к действию пищеварительных ферментов человека ( связи между фруктозой и глюкозой, с короткоцепочечными жирными кислотами) • Большинство бифидобактерий обладает соответствующим β-fructosidase
 Симбиотики • Смесь пробиотика и пребиотика. • В идеале –синергизм.
Симбиотики • Смесь пробиотика и пребиотика. • В идеале –синергизм.
 Пробиотики - будущее • Изолированы и охарактеризованы молекулярно-генетическими методами новые перспективные штаммы бифидобактерий. • С использованием технологии рекомбинантных ДНК получены генетически измененные штаммы. • создаются пробиотические штаммы с заданными уникальными свойствами.
Пробиотики - будущее • Изолированы и охарактеризованы молекулярно-генетическими методами новые перспективные штаммы бифидобактерий. • С использованием технологии рекомбинантных ДНК получены генетически измененные штаммы. • создаются пробиотические штаммы с заданными уникальными свойствами.
 В нашей лаборатории созданы оригинальные векторные системы: Для получения рекомбинантных бифидобактерий-продуцентов фактора роста фибробластов и интерлейкина – 10 цитокинов (ИЛ-10 способен уменьшать продукцию ИЛ-1, фактора некроза опухолей, ИЛ-6 макрофагами), является противовоспалительным цитокином. Эти штаммы перспективны для лечения неспецифического язвенного колита болезни Крона язвенно-некротического энтероколита недоношенных.
В нашей лаборатории созданы оригинальные векторные системы: Для получения рекомбинантных бифидобактерий-продуцентов фактора роста фибробластов и интерлейкина – 10 цитокинов (ИЛ-10 способен уменьшать продукцию ИЛ-1, фактора некроза опухолей, ИЛ-6 макрофагами), является противовоспалительным цитокином. Эти штаммы перспективны для лечения неспецифического язвенного колита болезни Крона язвенно-некротического энтероколита недоношенных.
 Пробиотики - будущее • Развитие генной инженерии бифидобактерий позволит создавать пробиотические штаммы бифидобактерий с заданными свойствами – способными продуцировать рекомбинантные человеческие белки – цитокины, ферменты, антитела.
Пробиотики - будущее • Развитие генной инженерии бифидобактерий позволит создавать пробиотические штаммы бифидобактерий с заданными свойствами – способными продуцировать рекомбинантные человеческие белки – цитокины, ферменты, антитела.


